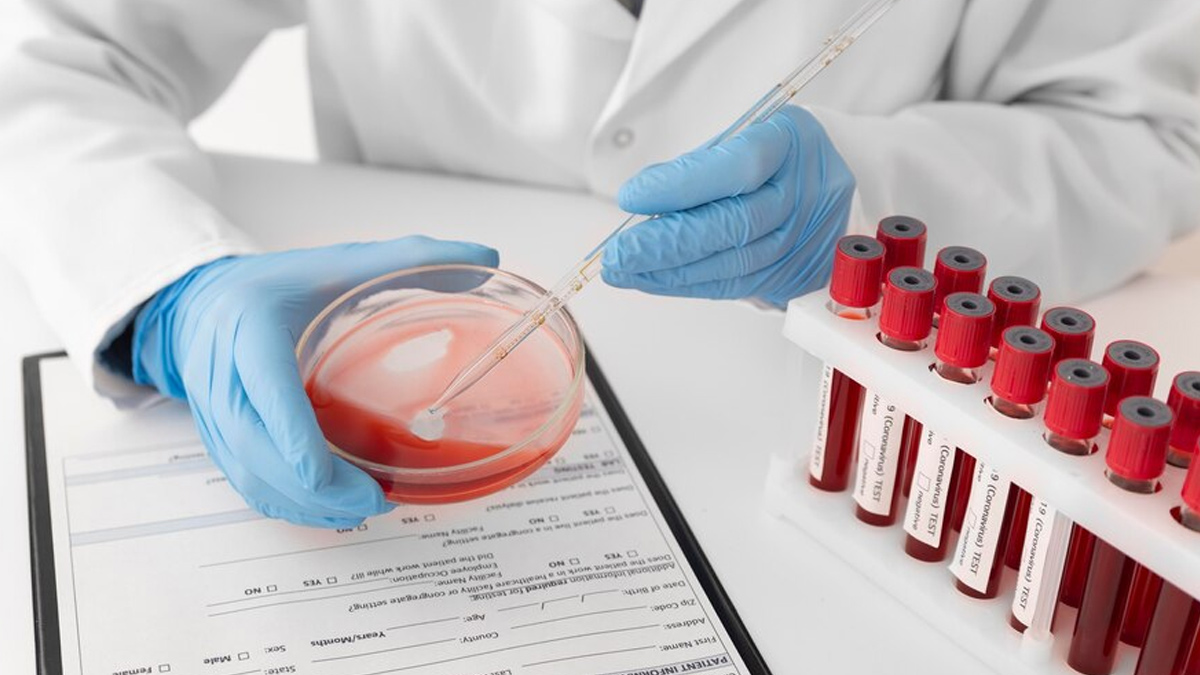

Red Blood Cells (RBCs), also called erythrocytes, are one of the most important components of blood. They contain a protein called haemoglobin that helps carry oxygen from the lungs to other parts of the body. But have you ever wondered how much of your blood actually contains RBCs? That's what a hematocrit test checks. This simple blood test is usually part of the Complete Blood Cell (CBC) test, which is often recommended by doctors during a routine health checkup. But why is it important to get a hematocrit test, and when should it be taken? Speaking with the OnlyMyHealth team, Dr Vigyan Mishra, Chief of Lab, Neuberg Diagnostics, Noida, sheds light.
Table of Content:-
Also Read: How to Increase White Blood Cells and Supercharge Your Defenses
Why Should You Get A Hematocrit Test?
According to Dr Mishra, a hematocrit test measures the proportion of RBCs in the blood, providing essential information about a person’s overall health.
As discussed, it is usually a part of the CBC test, which measures the seven types of blood cells, such as RBCs, neutrophils, eosinophils, basophils, lymphocytes, monocytes, and platelets.
As per the Mayo Clinic, when the hematocrit levels are low, the proportion of RBCs in the blood is lower than usual, which could indicate anaemia, a certain vitamin or mineral deficiency, or a recent or long-term blood loss.
Therefore, you should consider getting a hematocrit test if you experience symptoms such as persistent fatigue, weakness, dizziness, shortness of breath, or paleness, as these can be indicative of anaemia or other blood-related conditions, according to Dr Mishra.

On the other hand, if hematocrit levels are high, one must watch out for conditions such as dehydration, lung or heart disease, and disorders that cause your body to produce too many RBCs, such as polycythemia vera. In certain cases, living at a high altitude may also lead to high hematocrit measurements.
It is important to note that the percentage of RBCs measured by a hematocrit test can vary from person to person, depending on the age, sex, and even where the person lives. Generally, for males, a normal hematocrit falls between 41 and 50%, while for females, it's typically between 36 and 44%.
Therefore, if your results fall outside these ranges, it doesn't necessarily mean there's a problem, but your doctor may want to investigate further.
Also Read: Understanding The Possible Causes Of Blood Clots And How To Lower The Risk
When Should You Consider Taking a Hematocrit Test?

Dr Mishra says, “A hematocrit test is important if you have a history of chronic diseases like kidney disease, cardiovascular problems, or a family history of blood disorders.”
He adds that this test is often recommended during routine health check-ups to monitor your general health and detect potential issues early.
According to him, it is also commonly performed before surgeries, during pregnancy, or if you are undergoing treatments that might affect blood cell production, such as chemotherapy.
Bottomline
When you go for a routine health checkup, you will likely be recommended a CBC test, which includes several components, one of which is the hematocrit test. It helps diagnose and monitor conditions like anaemia, dehydration, polycythemia, and bone marrow disorders, enabling timely and appropriate medical interventions. Hence, it is important to recognise the importance of regular monitoring through this test, as it can aid in managing chronic conditions and maintaining optimal health.
Also watch this video
How we keep this article up to date:
We work with experts and keep a close eye on the latest in health and wellness. Whenever there is a new research or helpful information, we update our articles with accurate and useful advice.
Current Version